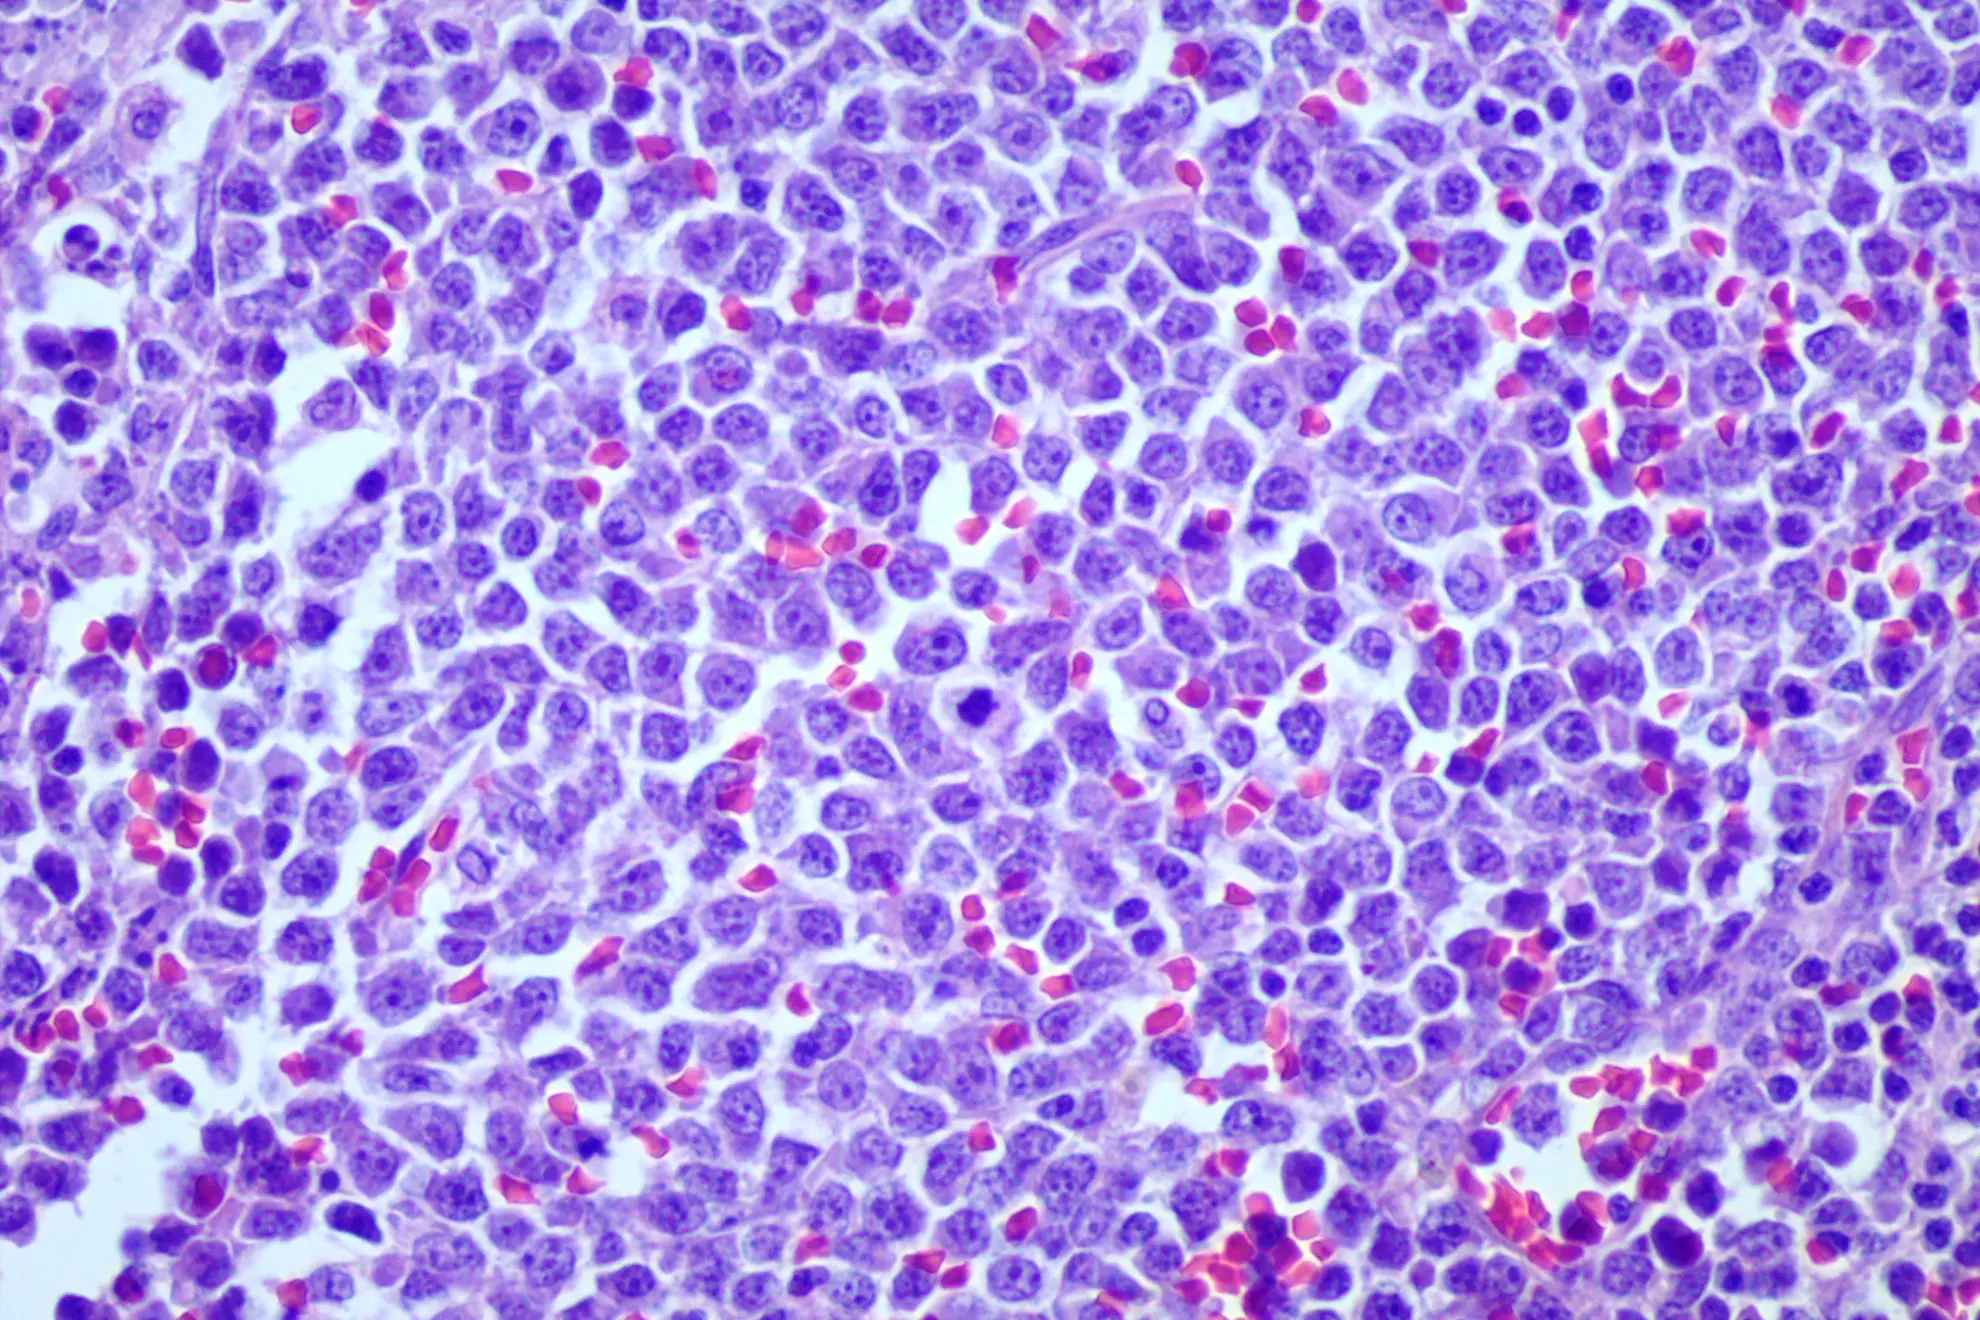
Patología Oncológica
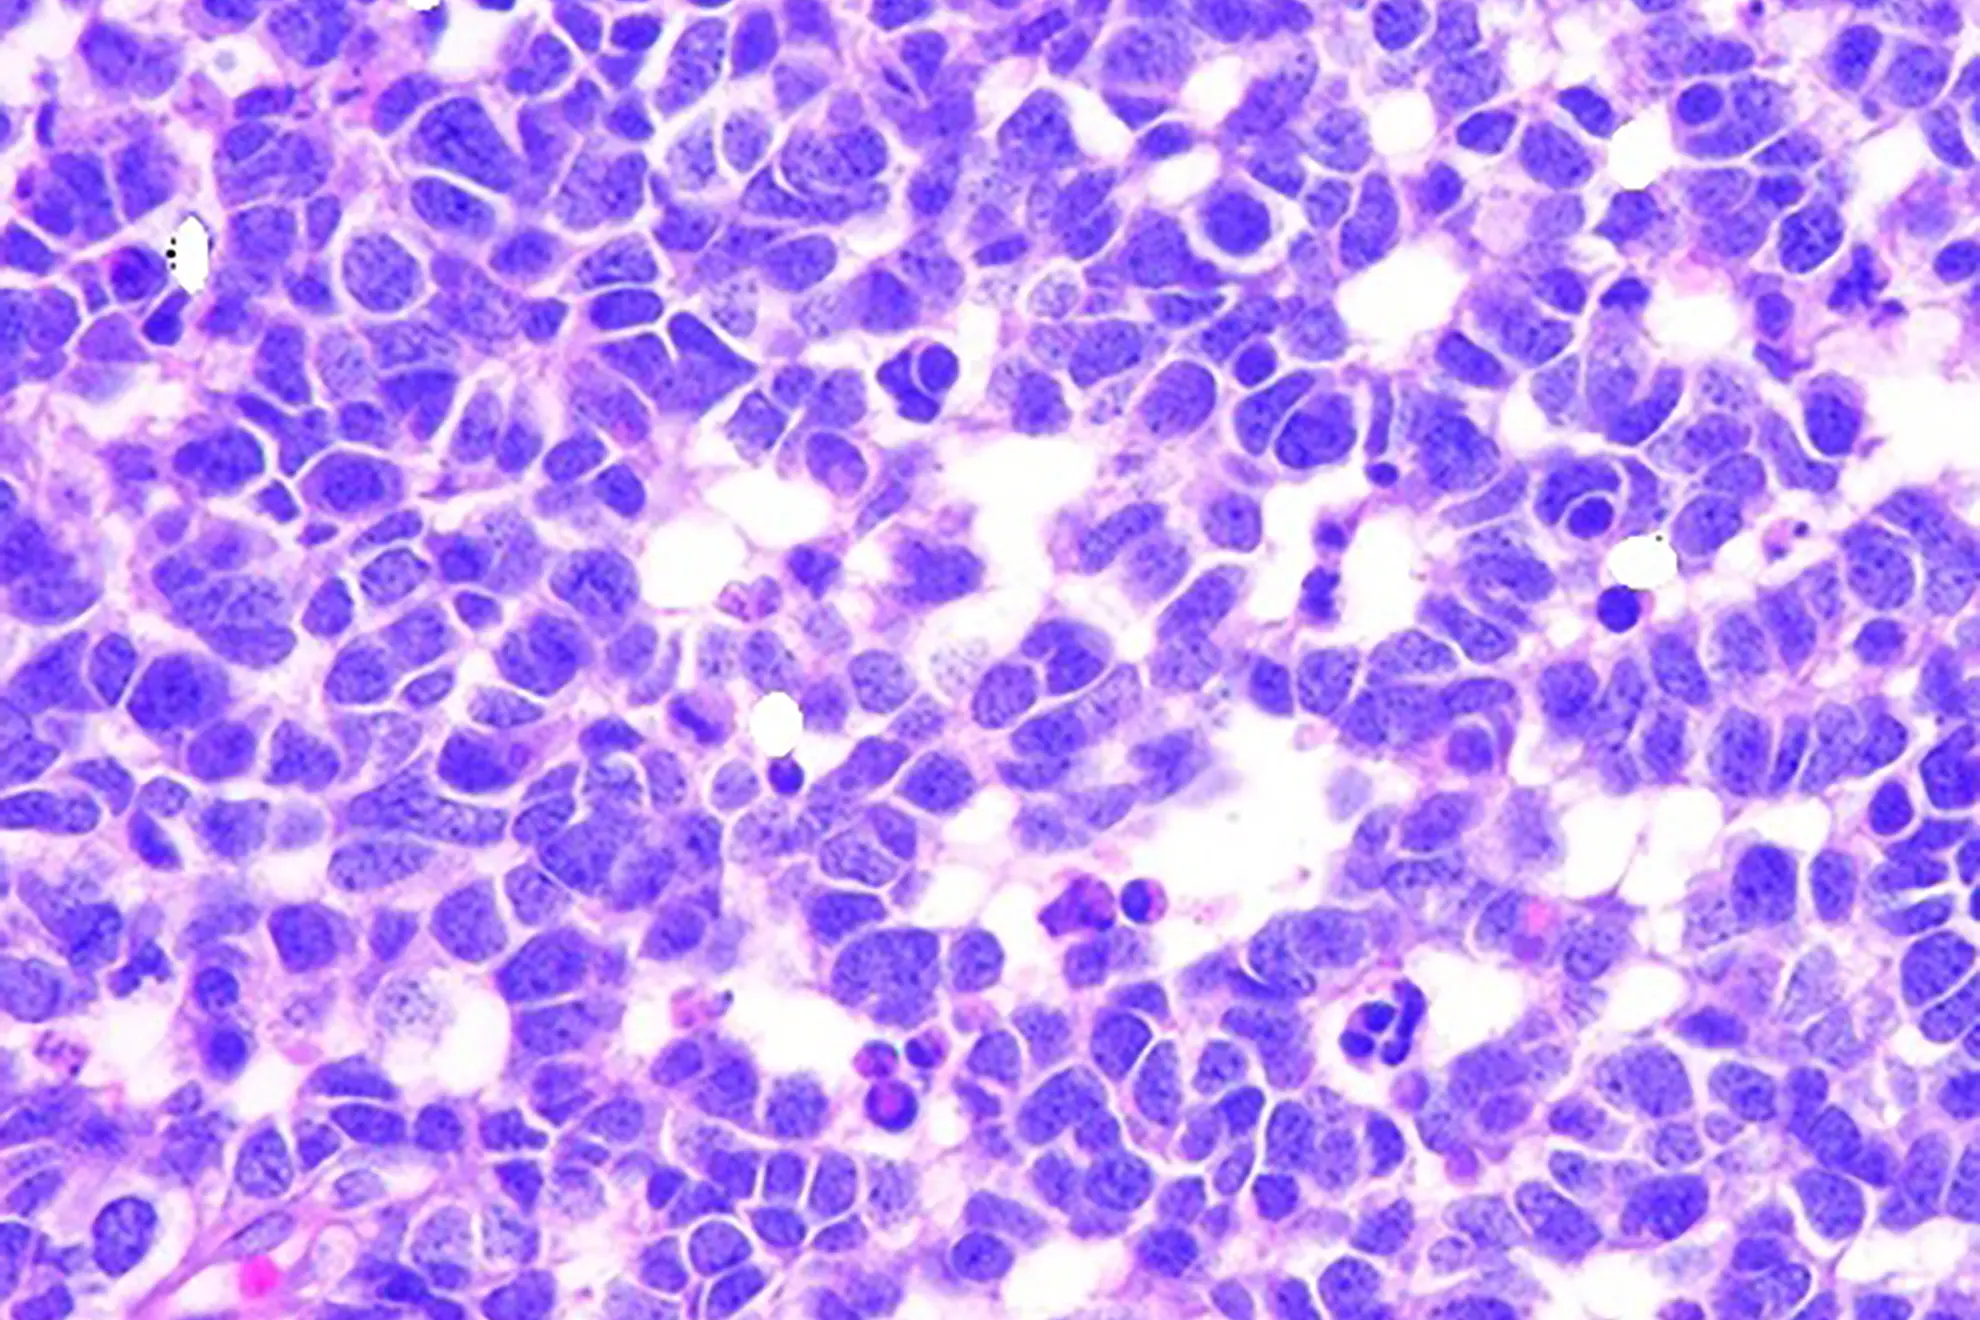
Neuropatología

¡Bienvenido a nuestro Laboratorio de Patología, donde la excelencia diagnóstica es nuestra prioridad, para apoyarte en el cuidado de tus pacientes! En el Laboratorio de Patología de UMG Labs, te ofrecemos diagnósticos confiables y oportunos, respaldados por más de 10 años de experiencia y una sólida cooperación clínico-patológica que garantiza la precisión de nuestros resultados.
Escribe el nombre del estudio para saber preparaciones y detalles.

Puedes contactárnos buscándonos por Waze, escribiendo a nuestro correo electrónico o completando este formulario de contacto.